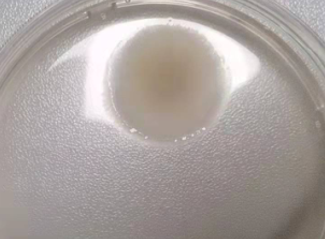

细胞培养人最怕的事:污染突袭!
你是否经历过 —— 精心养了一周的细胞,突然出现不明颗粒、培养基变浑浊、生长速度骤降?这大概率是细胞污染找上门了!污染不仅让前期努力付诸东流,还可能影响实验数据准确性,成为科研路上的 “绊脚石”。今天就带大家全面解锁细胞污染防治秘籍,从源头规避风险,遇到污染也能冷静应对~
细胞污染主要分 4 类
1. 细菌污染(最常见)


变浑浊的培养基(图片来源于网络) 细菌污染(图片来源于网络)
Ø 形态特征:细菌的个体非常小,结构简单,无细胞核、细胞器,目前已知最小的细菌只有0.2 μm。细菌呈现三种基本形状:球形(球菌)、杆状(芽孢杆菌)或弯曲(弧菌、螺菌)。
Ø 污染特征:细菌污染时细胞培养基可能在4-6小时呈现浑浊,显微镜下可见大量细小的黑色颗粒,细胞形态逐渐皱缩、脱落,呈现病怏怏的状态。
Ø 解决方案:CSP006, 0513青霉素- 链霉素混合溶液
2. 真菌污染(隐蔽性强)
酵母菌污染(图片来源于网络) 霉菌污染(图片来源于网络)
Ø 形态特征:常见的真菌主要为酵母菌和霉菌两大类。酵母菌是单细胞结构,无菌丝,个体呈球形、卵圆形或椭圆形,直径通常在 3~5 μm,呈现出芽生殖的特征; 霉菌呈纤细的丝状、管状结构或絮状 、绒毛状的结构。
Ø 污染特征:初期培养基清澈,后期出现白色 / 黄色絮状沉淀,或镜下可见丝状菌丝、孢子,细胞生长缓慢直至停滞。
Ø 解决方案: CSP007青霉素- 链霉素- 两性霉素B 混合溶液, CSP066青霉素-链霉素-新霉素溶液, CSP246真菌/霉菌清除试剂

3. 支原体污染(“隐形杀手”)


形态各异的支原体(图片来源于网络) 被支原体“附身”的HT1080(图片来源于网络)
Ø 形态特征:支原体大小为0.15~0.3 μm,在光学显微镜下无法观察到支原体,需使用电子显微镜。支原体形态各异,有球状、环状、丝状、分枝状。
Ø 污染特征:支原体污染的培养基无明显变化,细胞逐渐出现形态异常(如变大、扁平)、增殖变慢,严重时核质比异常。
Ø 解决方案:CSP037支原体清除试剂,CSP201支原体高效预防试剂
4. 黑胶虫污染(“神秘杀手”)


黑胶虫污染视频1(来源于客户) 黑胶虫污染视频2(来源于客户)
Ø 形态特征:黑胶虫通常在镜下呈卵圆状或球杆状小黑点,并呈现布朗运动以及明显的增殖现象。
Ø 污染特征:培养基一般不浑浊,复苏或传代时易出现黑胶虫污染,并且与细胞呈现此消彼长的现象,严重时会造成细胞裂解和凋亡。
Ø 解决方案:CSP093黑胶虫清除试剂
预防为王:5 个关键环节守住防线
1. 环境消毒:打造无菌 “堡垒”
Ø 超净台/生物安全柜使用前用 75% 酒精擦拭,紫外照射 30 分钟;
Ø 实验室地面、桌面每周用含氯消毒剂/滴露彻底清洁,定期检测空气沉降菌;
Ø 操作时佩戴一次性手套、口罩,手套接触非无菌物品后立即更换。
2. 试剂耗材:从源头把控质量
Ø 选择正规渠道的培养基、血清、胰酶的相关试剂;
Ø 耗材(离心管、培养皿、移液管),开封后尽快使用,避免反复开盖暴露。
3. 操作规范:细节决定成败
Ø 所有操作在超净台/生物安全柜内进行,避免手臂跨越培养瓶 / 皿上方,移液时动作轻柔,减少气泡产生(气泡易携带细菌);
Ø 不同细胞系分开操作,使用专用移液管、培养基,避免细胞交叉污染;
Ø 定期检查培养箱湿度、CO₂浓度,托盘内加入无菌水(可加少量抗生素抑制细菌滋生)。
4. 定期监测:早发现早处理
Ø 每天观察细胞形态、培养基颜色,怀疑污染时及时镜检;
Ø 定期进行支原体检测(PCR 法、荧光染色法),建议每 1-2 个月筛查一次,新购入细胞优先检测。
5. 应急处理:污染后别慌!
Ø 轻微污染:若细胞状态尚可,可加入适量抗生素(如青霉素 - 链霉素双抗、支原体清除剂),连续培养 2-3 代,期间密切观察,若污染未控制则果断丢弃;
Ø 严重污染:直接丢弃污染细胞及培养基,相关耗材高压灭菌处理,超净台/生物安全柜、培养箱用酒精 + 紫外彻底消毒,避免污染扩散。
�� 预防为主,防治结合
细胞污染防治的核心是 “预防为主,防治结合”,规范操作、严格消毒、定期监测三者缺一不可。若要抢救污染的细胞,可使用抗生素,但不要过度依赖抗生素,长期使用易导致耐药性,更不能抱有侥幸心理 —— 一次不规范操作,就可能让所有努力归零!
希望这篇指南能帮大家避开污染 “坑”,让细胞健康生长,实验顺利推进!